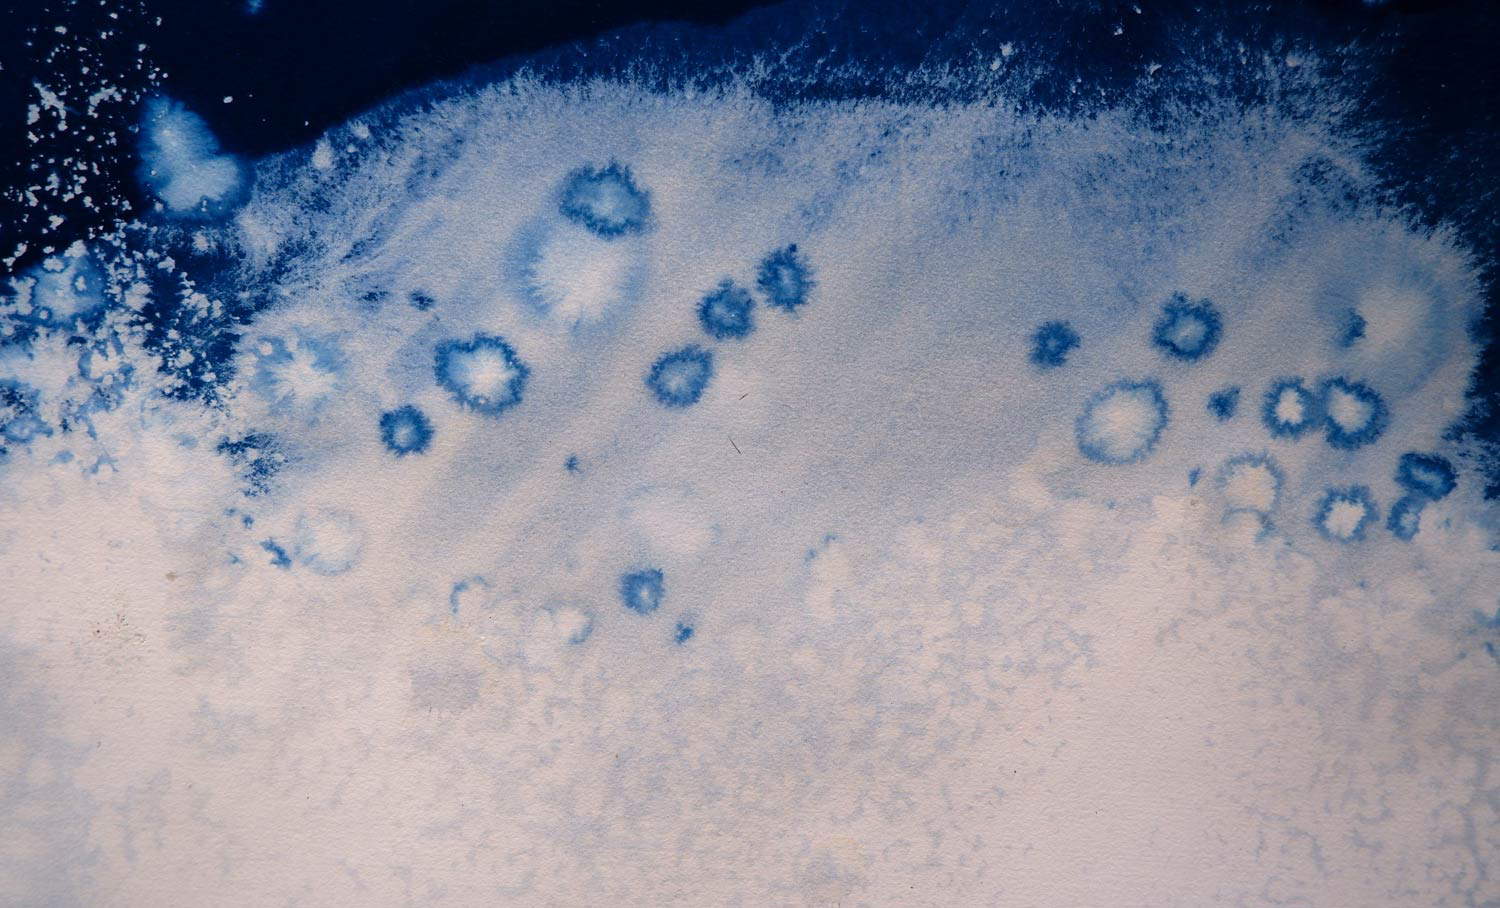

È ormai chiaro: la sostenibilità ambientale è determinante anche in ambito museale e nel quadro dei progetti artistico-culturali. Sia con la ratifica della Convenzione di Faro da parte del Governo italiano (settembre 2020) in cui si sono aperte nuove prospettive per una museologia più coerente con l’aggiunta dell’interesse per una crescita sostenibile del museo, sia con la recente Dichiarazione di Roma, approvata all’unanimità dal G20 della Cultura, in cui si incoraggiano piani di sviluppo sostenibili, ciò che sta emergendo (e che sarà reso ancora più evidente anche da una pubblicazione prossima a cura di Maurizio Vanni) è un impegno, ormai largamente profuso, rivolto da un lato a fronteggiare la minaccia critica e urgente dei cambiamenti climatici e dall’altro a lavorare insieme perché l’UNFCCC (United Nations Framework Convention on Climate Change) di Glasgow abbia successo.
A questi progetti ecosostenibili però devono unirsi tantissimi altri programmi come quelli volti al risparmio e all’efficienza energetica, che abbiano l’obiettivo di ricorrere a energie rinnovabili nonché nuove ricerche di studio percorribili anche mediante progetti di ricerca e residenza. Uno di questi, tra i più significativi, è in corso in Groenlandia: The Greenland Project dell’artista Roberto Ghezzi (Cortona, 1978), a cura di Mara Predicatori, permetterà di approfondire il problema dello scioglimento dei ghiacciai. Il progetto, iniziato il 15 giugno e che durerà fino al 10 luglio, è pensato con una modalità alternativa: c’è infatti una stretta collaborazione tra l’artista e gli studiosi, in particolare con Biagio Di Mauro del CNR - ISP (Istituto di Scienze Polari) e prevede anche il supporto di The Red House di Robert Peroni e Phoresta Onlus e il contributo di Cartiera Enrico Magnani Pescia.
Sostenibilità, pensiero green, full nature immersion: queste le parole chiave della ricerca di Roberto Ghezzi, da sempre fondata su un forte interesse verso il paesaggio naturale. Indagato sia attraverso la rappresentazione pittorica che mediante indagini in situ, il suo lavoro muove da un approccio scientifico della realtà organica, assumendo identità estetica attraverso la materia.



Nello specifico della Groenlandia, la ricerca di Ghezzi che si sta concentrando nello studio del fenomeno dello scioglimento dei ghiacciai, e le sue indagini saranno impresse su supporti specifici come le carte foto, sensibilizzate mediante il metodo della cianotipia, che sono lasciate interagire con il ghiaccio durante il suo cambiamento di stato. Lo strumento è utile per permettere alle tracce lasciate dal fenomeno in corso d’osservazione di essere memoria artistica e scientifica.
Dai primi giorni di residenza e grazie alla collaborazione con gli studiosi stanno emergendo interessanti indizi e novità. “Alcune alghe presenti anche in Groenlandia”, come spiega il dottor Di Mauro, “accelerano lo scioglimento dei ghiacciai dell’Artico scurendo la superficie della neve e contribuendo all’assorbimento del calore”. Insomma la residenza, molto documentata (video, foto, carte sensibilizzate, taccuino) di Ghezzi sta consentendo un importante avanzamento negli studi anche scientifici del fenomeno dello scioglimento dei ghiacciai: sembra infatti, che la “neve rossa” riduca l’albedo di almeno il 13% durante l’estate. E questo è un dato fondamentale che sarà seriamente preso in considerazione.
Roberto Ghezzi, classe 1978, ha maturato una lunga esperienza in ambito di progettazione del paesaggio, cercando nell’ibridazione tra studi scientifici, Land Art ribaltata e intervento umano nuove riflessioni e connessioni sperimentandone gli esiti direttamente nella natura. Naturografie, per esempio, termine da lui coniato, è stato un progetto che ha incarnato appieno la ricerca di Ghezzi e in cui, come per il progetto in corso in Groenlandia, ha scelto precisamente il luogo d’indagine e poi d’installazione.

Ogni suo lavoro presuppone un periodo di attesa e osservazione del fenomeno che si vuole indagare, procedendo con la messa a punti del materiale lasciato interagire con l’ambiente. Nel caso di The Greenland Project, Ghezzi lavora nello stesso punto per circa venticinque giorni, realizzando cianotipie della stessa zona al fine di “fotografare” il fenomeno della liquefazione dal suo interno, e quindi dell’arretramento del ghiaccio, giorno per giorno, in un determinato luogo. In tal modo si produrrà un’immagine chiara ed inequivocabile del fenomeno del ghiacciaio in arretramento (e della velocità con cui tale processo avviene), con una propria estetica ben delineata.
L’obiettivo della sua ricerca è così demandare al tempo e lasciar dire e fare alla Natura il completamento dell’opera. La luce, i minerali, le acque e gli organismi che vivono in quella zona prescelta agiscono in modo da creare altri paesaggi, sempre vivi e diversi. Roberto Ghezzi ha effettuato decine di residenze artistiche, ricerche sperimentali e installazioni ambientali, oltre che in Italia, anche in luoghi remoti del pianeta come l’Alaska, l’Islanda, il Sudafrica, la Norvegia, la Tunisia e la Patagonia.
Per inviare il commento devi
accedere
o
registrarti.
Non preoccuparti, il tuo commento sarà salvato e ripristinato dopo
l’accesso.